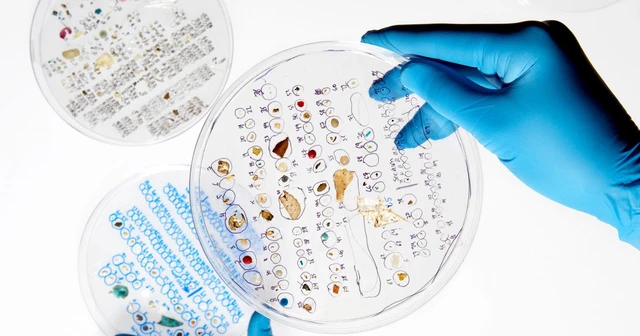
Nghiên cứu tìm thấy hạt vi nhựa trong gạo: Bạn nên hay không nên vo gạo trước khi nấu? - Ảnh 7. Nghiên cứu tìm thấy hạt vi nhựa trong gạo: Bạn nên hay không nên vo gạo trước khi nấu? - Ảnh 7.

Nghiên cứu tìm thấy hạt vi nhựa trong gạo: Bạn nên hay không nên vo gạo trước khi nấu?
Từng phản đối vo gạo vì làm mất chất dinh dưỡng, các nhà khoa học Phương Tây bây giờ nói vo gạo là tốt vì nó giúp loại bỏ hạt vi nhựa.
- Lần đầu tìm thấy hạt vi nhựa trong mô tĩnh mạch của con người
- Thiết bị lọc nước loại bỏ 99,9% vi nhựa và chất ô nhiễm trong 10 giây
- Một vết xước nhỏ trên chảo chống dính có thể giải phóng hàng nghìn hạt vi nhựa
- Hạt vi nhựa: Nỗi xấu hổ về nền "văn minh" của chúng ta với hậu thế
- Đừng vội hoảng sợ với hạt vi nhựa trong nước uống, WHO chỉ ra nguy cơ gây hại sức khỏe thấp
Gạo là lương thực chính của hàng tỷ người trên thế giới tập trung ở Châu Phi, Châu Á, bao gồm cả Việt Nam. Tại các nước Phương Tây, gạo ít được ưa chuộng hơn lúa mì. Tuy nhiên, nhiều món ăn như dolma của Hy Lạp, risottos của Ý và bánh pudding gạo từ Vương quốc Anh vẫn cần gạo như một loại nguyên liệu chính.
Các nhà khoa học Phương Tây vì vậy không bỏ qua cách mà gạo được nấu thành cơm. Họ từng có nhiều nghiên cứu về vấn đề này, chẳng hạn như làm sao để nấu cơm vừa ngon, vừa thơm mà không sợ béo.
Tuy nhiên, vẫn có một vấn đề gây tranh cãi giữa truyền thống nấu cơm của người Phương Đông và khoa học dinh dưỡng của Phương Tây. Đó là việc: Liệu chúng ta có nên vo gạo trước khi nấu hay không?

Lợi ích và tác hại của việc vo gạo là gì? Ảnh: Cookist.
Theo quan niệm Á Đông, vo gạo là một bước không thể bỏ qua trong quy trình nấu cơm truyền thống. Trái lại, nghiên cứu của các nhà khoa học Phương Tây phát hiện vo gạo làm mất từ 70-95% các chất dinh dưỡng bên ngoài vỏ hạt gạo, bao gồm vitamin nhóm A, B, E, sắt, kẽm, omega 3 và chất xơ tốt.
Các đầu bếp Phương Tây vì vậy thường không ủng hộ việc vo gạo, nhất là với những món ăn đòi hỏi độ dính của cơm như risottos, paella và bánh pudding. Nhưng bây giờ, một nghiên cứu đăng trên tạp chí Journal of Hazardous Materials sẽ khiến họ phải nghĩ lại.
Liên minh các nhà khoa học đến từ Đại học Queensland (Australia), Đại học Cagliari (Italia) và Đại học Amsterdam (Hà Lan) cho biết chúng ta nên vo gạo trong thời đại ô nhiễm hạt vi nhựa, bởi gạo cũng có thể nhiễm vi nhựa và bằng cách vo, bạn có thể loại bỏ tới 0,9 mg nhựa bị nhiễm vào mỗi 100 gam gạo.
Nếu tính theo ước tính của Bộ Nông nghiệp và Phát triển Nông thôn, mỗi người Việt Nam ăn khoảng 96,6 kg gạo/năm thì bằng cách vo gạo, bạn có thể loại bỏ được 870 mg nhựa trong khẩu phần ăn của mình.
Một cách trực quan, 870 mg bằng với cân nặng của 3 hạt ngô. Và bạn chắc chắn sẽ không muốn nuốt 3 hạt ngô bằng nhựa vào bụng mình đâu đúng không?
Gạo cũng bị nhiễm hạt vi nhựa
Các nhà khoa học định nghĩa hạt vi nhựa là những mảnh nhựa có kích thước nhỏ hơn 5 mm. Điều đó có nghĩa là vi nhựa đôi khi có thể nhìn thấy được bằng mắt thường. Nhưng phần lớn thời gian, các hạt vi nhựa tồn tại ở kích thước micromet, cá biệt có những hạt vi nhựa nhỏ tới mức nano với đường kính bé hơn 0,001mm – mỏng gấp 10 lần đường kính sợi tóc.
Ở những kích thước này, hạt vi nhựa không thể được nhìn thấy bằng mắt thường. Vì vậy, các nhà khoa học cho biết con người đang ăn hàng chục ngàn hạt vi nhựa vào từ thực phẩm mỗi năm mà không hề hay biết.

Con người đang ăn hàng chục ngàn hạt vi nhựa vào từ thực phẩm mỗi năm mà không hề hay biết. Ảnh: Adobe.
Năm 2018, hạt vi nhựa đã được phát hiện thấy trong mật ong, đường, bia, thậm chí cả muối. Theo đó, 1 kg muối biển có thể chứa hơn 600 hạt vi nhựa. Nếu bạn ăn 5 gam muối mỗi ngày, điều này có nghĩa là bạn cũng tiêu thụ 3 hạt vi nhựa trong đó.
Năm 2019, Tổ chức Y tế Thế giới (WHO) cho biết tới 93% mẫu nước đóng chai bị nhiễm hạt vi nhựa. Trung bình, mỗi lít nước sẽ chứa 325 hạt vi nhựa, cá biệt, có những mẫu nước chứa tới hơn 10.000 hạt vi nhựa/lít.
Năm 2020, hạt vi nhựa tiếp tục được tìm thấy trong sữa, rau tươi, rong biển… Tuy nhiên, chưa có nghiên cứu nào điều tra ô nhiễm hạt vi nhựa trong gạo – loại lương thực chính của hơn một nửa dân số thế giới và đang cung cấp hơn 20% năng lượng trong chế độ ăn của nhân loại.
Để tìm hiểu điều này, một nhóm các nhà khoa học Australia đã lấy mẫu gạo được bán ra tại các siêu thị ở miền đông nam Queensland và phân tích chúng bằng kỹ thuật chiết lỏng áp suất và sắc ký khí – những cỗ máy hiện đại không chỉ tìm ra được hạt vi nhựa mà còn cho biết chúng thuộc loại nhựa nào dựa trên phân tử hóa học được tìm thấy.
Kết quả cho thấy bất kể gạo được đóng gói trong bao bì giấy, nilon hay vải, lượng hạt vi nhựa được tìm thấy trong mẫu thu thập được đều tương đương nhau. Cứ 100 g khẩu phần ăn thì có khoảng 3,7 mg hạt vi nhựa bị lẫn vào đó.


Cứ 100 g khẩu phần ăn thì có khoảng 3,7 mg hạt vi nhựa bị lẫn vào đó. Ảnh: Sciencedirect.
Mặc dù gạo đựng trong túi nhựa có nồng độ hạt vi nhựa cao hơn một chút, nhưng các nhà khoa học cho biết con số không có ý nghĩa về mặt thống kê. Ngoại trừ một trường hợp, đó là các hộp cơm ăn liền - chứa gạo đã nấu chín và chỉ cần bỏ vào lò vi sóng - chúng có nồng độ hạt vi nhựa cao hơn gấp 4 lần so với gạo sống.
Các loại hạt vi nhựa được tìm thấy trong gạo bao gồm: polyetylen, polyetylen terephthalat, poly-(metyl metacryit), polypropylen , polystyren và polyvinyl clorua. Dựa trên mức tiêu thụ gạo hàng năm ở Australia, các nhà khoa học ước tính mỗi năm, một người dân nước này phải ăn vào 1 g hạt vi nhựa từ gạo.
Điều gì có thể xảy ra nếu bạn ăn vào hạt vi nhựa?
Theo Tiến sĩ Flemming Cassee, một giáo sư về độc học tại Đại học Utrecht, Hà Lan, có ba mối nguy hiểm tiềm ẩn của hạt vi nhựa xuất phát từ: (1) sự hiện diện vật lý của chúng trong cơ thể, (2) cấu tạo của hạt vi nhựa và (3) hóa chất mà chúng mang theo.
Nói về sự hiện diện, một nghiên cứu năm 2020 đã tìm thấy hạt vi nhựa có trong 47 mô nội tạng bao gồm phổi, gan, lá lách và thận của con người. Điều đó ngụ ý rằng các hạt vi nhựa có thể thâm nhập vào máu người thông qua đường hô hấp hoặc đường tiêu hóa.
Tiến sĩ Nienke Vrisekoop, một phó giáo sư tại Đại học Utrecht cho biết các hạt vi nhựa trong máu có thể kích hoạt phản ứng miễn dịch không mong muốn của cơ thể.
Khi một tế bào bạch cầu hấp thụ một khối lượng vi nhựa nhất định - có thể là nhiều hạt nhỏ hoặc một hạt lớn đơn lẻ - nó sẽ chết, giải phóng các enzym gây viêm cục bộ.
Phản ứng này bình thường là để chống lại vi khuẩn và virus, nhưng sau khi vi khuẩn và virus đã bị tiêu diệt, phản ứng viêm cũng sẽ thuyên giảm.
Với hạt vi nhựa thì khác, vì nhựa không bị phân hủy, chúng sẽ kích thích phản ứng viêm kéo dài. "Điều này có thể dẫn đến nhiều tác dụng phụ, bao gồm hiện tượng căng thẳng oxy hóa, giải phóng các cytokine kích hoạt phản ứng viêm", tiến sĩ Vrisekoop nói.

Các phản ứng viêm mạn tính này là khúc dạo đầu cho nhiều căn bệnh, từ tim mạch, Parkinson cho đến cả trầm cảm và ung thư. "Các hạt vi nhựa nhỏ - có kích thước dưới 1/10 micromet – khi xâm nhập sâu vào phổi và thậm chí vào máu có thể gây tổn thương cho tim, mạch máu và não", Dick Vethaak, một giáo sư độc học sinh thai đến từ Đại học Vrije, Hà Lan cho biết thêm.
"Bằng chứng trực tiếp cho điều này đã được tìm thấy trên các công nhân ngành dệt may và ngành nhựa, những người tiếp xúc với một lượng sợi và bụi nhựa rất cao".
Về cấu trúc, các hạt vi nhựa có thể đóng vai trò như chất mang. Tiến sĩ Hanna Dusza đến từ Viện Khoa học Đánh giá Rủi ro tại Đại học Utrecht, cho biết:
"Các hạt vi nhựa trong môi trường có thể hút [hóa chất] như một miếng bọt biển. Những hóa chất này được biết đến là chất gây ô nhiễm, như thuốc trừ sâu, hợp chất flo hóa, chất chống cháy, v.v."
Khi vào cơ thể, các hóa chất này có thể được giải phóng, có khả năng dẫn đến ung thư, viêm mãn tính hoặc các tác dụng phụ chưa biết khác.
Các hạt vi nhựa cũng có thể hoạt động như một vật chuyên chở vi sinh vật, vi khuẩn và virus. Một nghiên cứu vào tháng 9 năm 2022 cho thấy virus truyền nhiễm có thể tồn tại 3 ngày trong nước ngọt bằng cách "quá giang" trên hạt vi nhựa.
Bản chất xốp của cấu trúc vi nhựa cung cấp cho vi khuẩn một môi trường hoàn hảo để sống và sinh sản, tiến sĩ Dusza nói. Vì vậy, nếu bạn ăn phải hạt vi nhựa, nhiều khả năng bạn cũng sẽ ăn phải vi khuẩn.

Nghiên cứu trên tạp chí Journal of Hazardous Materials tìm thấy 3,7 mg hạt vi nhựa trong mỗi 100 g cơm gạo. Ảnh: Dailymail.
Nguy cơ lớn cuối cùng đến từ việc ăn phải hạt vi nhựa nằm ở các hóa chất mà tự chúng mang trên mình. Tiến sĩ Heather Leslie, một nhà nghiên cứu cấp cao tại Khoa Môi trường và Sức khỏe, Đại học Vrije, ví hạt vi nhựa giống như những bát mì spaghetti với nước sốt.
Sợi mì là phần chuỗi xương sống polymer cấu thành lên nhựa. Còn nước sốt là các chất chống cháy, chống oxy hóa và phụ gia được thêm vào nhựa để giúp chúng cứng, mềm hoặc dẻo hơn.
Một nghiên cứu năm 2021 đã xác định được hơn 10.000 hóa chất có trong nhựa. Tiến sĩ Duszsa cho biết hơn 2.400 hóa chất trong số này là các hóa chất đáng lo ngại, 901 hóa chất thậm chí còn bị cấm sử dụng trong bao bì thực phẩm.
Nhiều hóa chất trong số này sẽ hoạt động như các hợp chất gây rối loạn nội tiết, hoặc chất độc bắt chước hormone khi chúng xâm nhập vào cơ thể. "Đôi khi, ngay cả một liều lượng thấp của một số chất phụ gia này cũng có thể gây ra những tác dụng không mong muốn", Tiến sĩ Leslie nói.
Ví dụ, Bisphenol A (BPA) là một hóa chất được thêm vào nhựa để giúp chúng cứng hơn. Hóa chất này đã được tìm thấy trong 47 mô cơ quan nội tạng trong nghiên cứu năm 2020. Sự hiện diện của BPA là đáng lo ngại, bởi đây là một chất gây rối loạn nội tiết nổi tiếng.
BPA có thể bắt chước estrogen, hormone sinh dục nữ cần thiết cho quá trình sinh sản, phát triển thần kinh và mật độ xương. Ở nam giới, estrogen điều chỉnh số lượng tinh trùng, ham muốn tình dục và chức năng cương dương.

Một nghiên cứu năm 2021 đã xác định được hơn 10.000 hóa chất có trong nhựa. Ảnh: Greeneration.
Phơi nhiễm BPA có liên quan đến nhiều bệnh bao gồm ung thư, ADHD, béo phì và số lượng tinh trùng thấp. Tiến sĩ Dusza cho biết hầu hết mọi người đều có một lượng BPA lưu thông trong máu, nhưng hạt vi nhựa có thể làm tăng mức độ phơi nhiễm của chúng ta, dẫn đến những hậu quả không mong muốn.
Và BPA mới chỉ là một trong số 2.400 hóa chất "đáng lo ngại" có thể bị "tan ra" từ hạt vi nhựa.
Vo gạo có thể giúp giảm 20% lượng hạt vi nhựa
Nếu như sự hiện diện của hạt vi nhựa trong gạo là một tin xấu, thì tin tốt là bạn có thể giảm phơi nhiễm bằng cách vo gạo.
Trong truyền thống của người Á Đông, vo gạo là một bước không thể thiếu trong quy trình nấu cơm vì nó có thể loại bỏ bụi bẩn, côn trùng, sặn và vỏ trấu còn sót lại từ quá trình xay xát gạo.
Thế nhưng, tại nhiều khu vực khác trên thế giới, đặc biệt là ở Phương Tây, bước vo gạo có thể bị bỏ qua vì nghiên cứu trước đó cho thấy vo gạo làm mất chất dinh dưỡng.
Vo gạo có thể làm giảm từ 70-95% các chất dinh dưỡng bên ngoài vỏ hạt gạo, bao gồm vitamin nhóm A, E, sắt, kẽm, omega 3 và chất xơ tốt. Nó cũng làm giảm 50-70% sắt, folate, niacin và thiamin là những vitamin nhóm B.
Tuy nhiên, nghiên cứu mới về sự hiện diện của hạt vi nhựa trong gạo có thể khiến quan niệm vo gạo của các quốc gia Phương Tây phải thay đổi. Các nhà khoa học cho biết quá trình vo gạo có thể giúp làm giảm 20% hạt vi nhựa từ gạo sống, và 40% hạt vi nhựa có trong sản phẩm cơm chín.
Thử nghiệm cho thấy sau khi vo gạo, hàm lượng vi nhựa đã giảm từ 3,7 mg/100g gạo sống xuống còn 2,8 mg/100g:


Vo gạo có thể giúp loại bỏ hơn 20% hạt vi nhựa bị nhiễm vào gạo. Ảnh: Sciencedirect.
Ngoài ra, gạo cũng được biết là loại lương thực chứa hàm lượng asen tương đối cao, do cây trồng hấp thụ nhiều asen trong nước hơn khi nó lớn lên. Vo gạo đã được chứng minh giúp loại bỏ khoảng 90% asen phơi nhiễm sinh học.
Một nghiên cứu khác đã xem xét sự hiện diện của kim loại nặng như chì và cadmium trong gạo. Các nhà khoa học sau đó cũng thấy việc vo gạo đã làm giảm từ 7-20% nồng độ của tất cả những chất độc này.
Vì vậy, câu chuyện vo gạo là một sự đánh đổi. Bạn phải lựa chọn giữa việc rửa trôi hạt vi nhựa và giữ lại hàm lượng chất dinh dưỡng có trong vỏ gạo. Đối với một số người, gạo chỉ cung cấp một tỷ lệ nhỏ các chất dinh dưỡng này. Nhưng đối với những người có khẩu phần ăn chính là gạo, nó có thể ảnh hưởng tới dinh dưỡng tổng thể.
Lời khyên tốt nhất là bạn vẫn nên vo gạo trước khi nấu, sau đó đảm bảo ăn đa dạng các loại thực phẩm khác. Điều này sẽ giúp bù đắp lượng chất dinh dưỡng đã mất đi từ quá trình vo gạo, đồng thời giúp bạn có một chế độ ăn lành mạnh, không phụ thuộc quá nhiều vào tinh bột.
Tham khảo Sciencedirect, WebMD, NPR, Theconversation, Nationalgeographic
NỔI BẬT TRANG CHỦ
-

Cũng dùng một loạt iPhone để quay, album trailer “HVL” của đạo diễn Việt khác gì bom tấn điện ảnh 28 Years Later?
Một công cụ, hai cách tiếp cận: album trailer “HVL” và 28 Years Later cho thấy sự khác biệt không đến từ thiết bị, mà từ cách nó được sử dụng.
-

Apple và MCK hợp tác thực hiện album trailer 360 độ quay bằng 8 chiếc iPhone 17 Pro